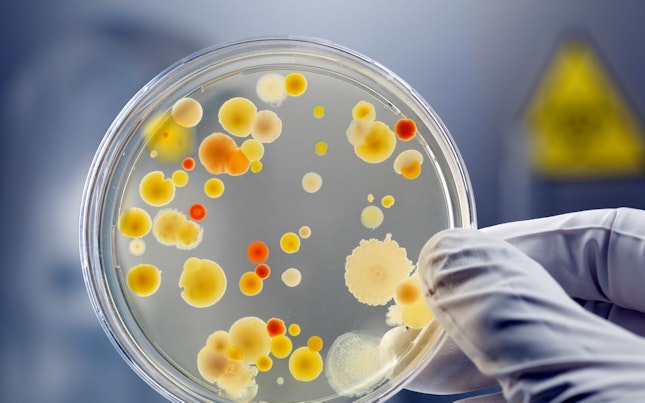
Hospital machine

When it comes to quality analytical controls for raw materials, APIs, finished products, packaging material and medical devices, you need precise results, reliable service and fast turnarounds. Our well-equipped, state-of-the-art laboratories offer comprehensive quality control testing services according to the pharmacopoeia (e.g. EP, USP, BP and JP) and to your specifications. With our global network of laboratories, you’ll benefit from a local service, fast turn-around times, and high quality analytical testing services. Our comprehensive range of analytical chemistry services is as follows:

Pharmaceutical Products
We offer testing for:
- Raw materials
- Excipients
- Active pharmaceuticals ingredients (API)
- Final product release testing
- In process release testing
- Personal care products
- Medical devices
- Packaging materials
- Containers
Chemicals Test Parameters
Our chemicals test parameters include:
- Identification
- Assay
- Impurities
- Dissolution
- Residual solvents
- Elemental impurities (heavy metals)
- Titration / Water (by Karl-Fisher)
Physical and Physico-chemical Test Parameters
Our physical and physico-chemical test parameters include:
- Description
- pH
- Conductivity
- Total organic carbon
- Viscosity
- Density
- Specific gravity
- Refractive index
- Water activity
- Disintegration melting point
- Particle size distribution (wet/dry)
- Particulate matter
- Particulate osmolality and osmolality
- Flash point
- Moisture determination (we still use the term LoD)
- Limit tests
- Hardness
- Friability
- Sulphated ash
- Anions
- Volatile organic compounds (VOC)
- Slide and static friction testing
- Bubble Point
- Specific/Optical rotation
- Organic volatile impurities (OVI)


Key Analytical Techniques
We offer you a wide range of analytical techniques, including:
Spectroscopy:
- UV/Vis
- FTIR
- Atomic absorption spectroscopy – flame / graphite / VGA
- ICP-OES and ICP-MS
Chromatographic tests:
- TLC
- HPLC/UPLC (with UV, PDA, FLD, RI, Corona, ELSD – Detectors)
- GC/HS (with TCD/FID/MS – Detectors)
Looking for something specific?
Search within Quality Control Release Testing for Pharmaceutical Products
Related Links
The Garden Center, Kawasan Komersial Cilandak (KKC), Jl. Raya Cilandak KKO,
12560,
South Jakarta, Special Capital Region of Jakarta, Indonesia